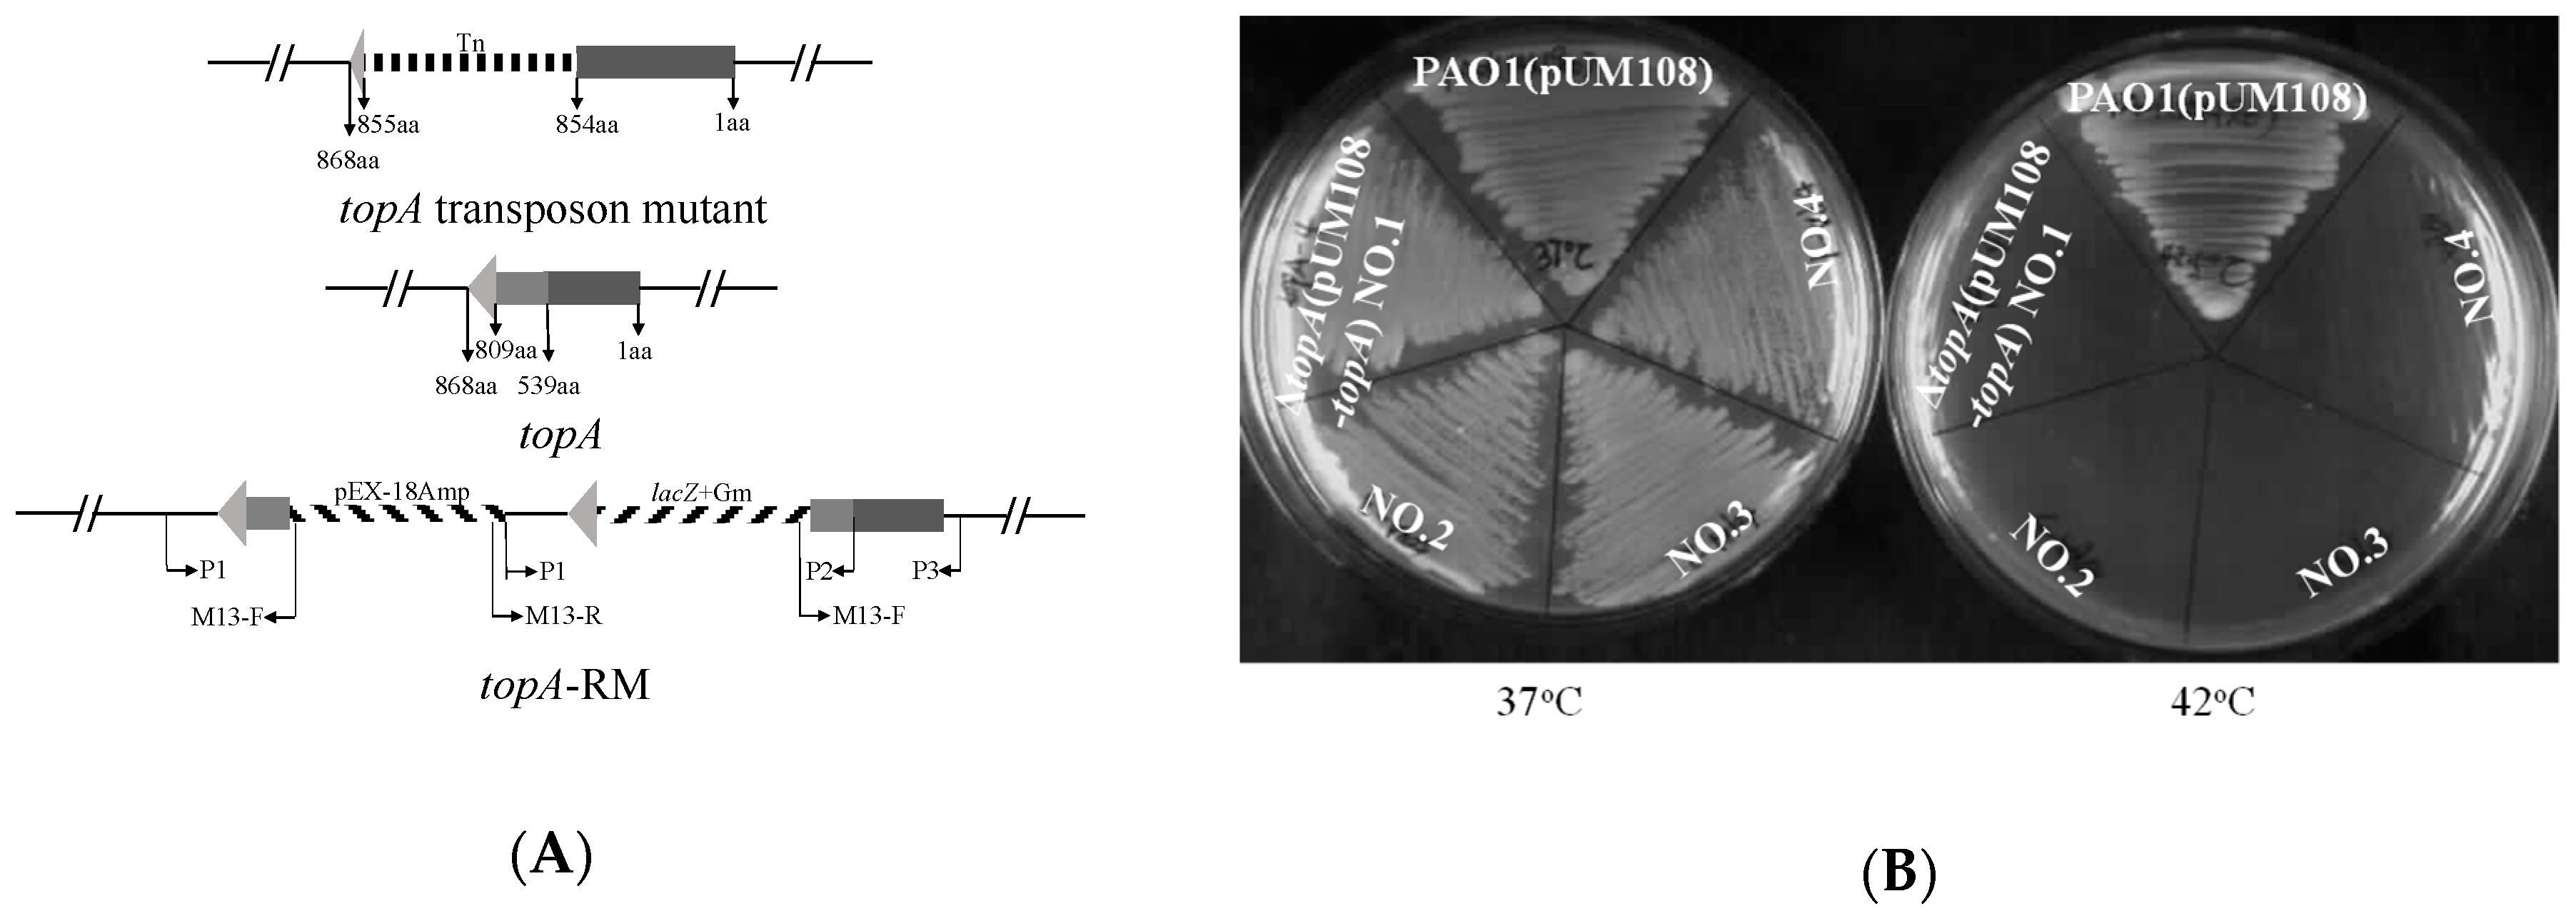
Ijms 20 01116 g001
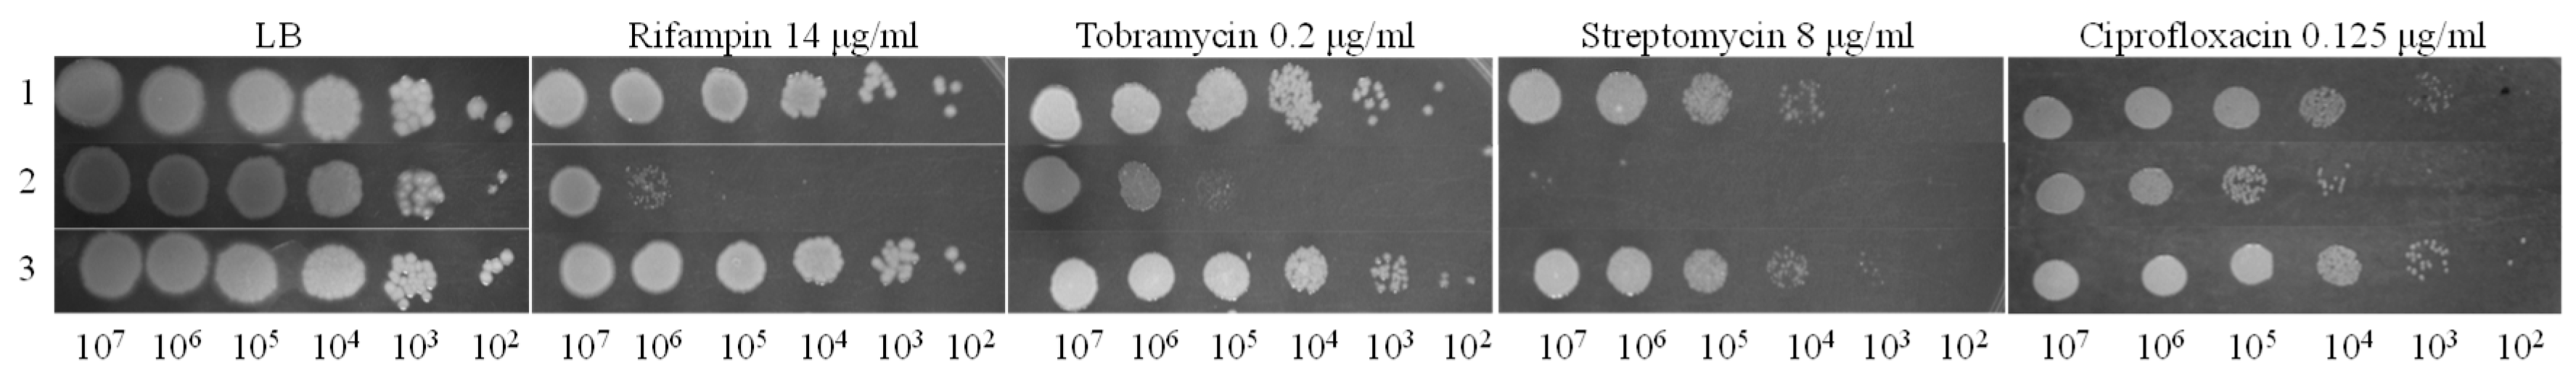
Ijms 20 01116 g004

Regulatory Effect of DNA Topoisomerase I on T3SS Activity, Antibiotic Susceptibility and Quorum- Sensing-Independent Pyocyanin Synthesis in Pseudomonas aeruginosa
Abstract
1. Introduction
2. Results
2.1. TopA Is Essential for Cell Viability in P. aeruginosa
2.2. Impaired TopA Has Pleotropic Effects on T3SS Expression, Phenazine Production, Antibiotic Susceptibility and Biofilm Formation
2.3. DNA Supercoiling Is Elevated as a Result of Impaired TopA
2.4. Transcriptional Activity of T3SS and Production of Secreted Effectors Correlate with TopA Activity but not DNA Supercoiling
2.5. Elevated PYO Production Requires PrtN
2.6. Quorum Sensing Is Not Involved in the Elevated PYO Production in topA-RM
3. Discussion
4. Materials and Methods
4.1. Stains, Plasmids and Growth Conditions
4.2. Construction of Mutant Strains
4.3. Construction of lux-Based Expression Reporter and the Measurement of Expression Levels
4.4. Complementation of Mutants
4.5. Measurement of Pyocyanin Production
4.6. Measurement of QS Signals
4.7. Initial Biofilm Formation Assay
4.8. Bacterial Motility Assay
4.9. Chloroquine Gel Electrophoresis
4.10. Protein Secretion Measurement
4.11. Statistical Analysis
Supplementary Materials
Author Contributions
Funding
Conflicts of Interest
References
- Bush, N.G.; Evans-Roberts, K.; Maxwell, A. DNA Topoisomerases. EcoSal Plus 2015, 6. [Google Scholar] [CrossRef] [PubMed]
- Dorman, C.J. DNA supercoiling and environmental regulation of gene expression in pathogenic bacteria. Infect. Immun. 1991, 59, 745–749. [Google Scholar] [PubMed]
- Dorman, C.J. DNA supercoiling and bacterial gene expression. Sci. Prog. 2006, 89 Pt 3–4, 151–166. [Google Scholar] [CrossRef] [PubMed]
- Dorman, C.J.; Dorman, M.J. DNA supercoiling is a fundamental regulatory principle in the control of bacterial gene expression. Biophys. Rev. 2016, 8 (Suppl. S1), 89–100. [Google Scholar] [CrossRef] [PubMed]
- Shortt, C.; Scanlan, E.; Hilliard, A.; Cotroneo, C.E.; Bourke, B.; Cróinín, T.Ó. DNA Supercoiling Regulates the Motility of Campylobacter jejuni and Is Altered by Growth in the Presence of Chicken Mucus. MBio 2016, 7, e01227-16. [Google Scholar] [CrossRef] [PubMed]
- Ferrandiz, M.J.; Martin-Galiano, A.J.; Arnanz, C.; Camacho-Soguero, I.; Tirado-Velez, J.M.; de la Campa, A.G. An increase in negative supercoiling in bacteria reveals topology-reacting gene clusters and a homeostatic response mediated by the DNA topoisomerase I gene. Nucleic Acids Res. 2016, 44, 7292–7303. [Google Scholar] [CrossRef] [PubMed]
- Cameron, A.D.S.; Stoebel, D.M.; Dorman, C.J. DNA supercoiling is differentially regulated by environmental factors and FIS in Escherichia coli and Salmonella enterica. Mol. Microbiol. 2011, 80, 85–101. [Google Scholar] [CrossRef] [PubMed]
- Ó Cróinín, T.; Carroll, R.K.; Kelly, A.; Dorman, C.J. Roles for DNA supercoiling and the Fis protein in modulating expression of virulence genes during intracellular growth of Salmonella enterica serovar Typhimurium. Mol. Microbiol. 2006, 62, 869–882. [Google Scholar] [CrossRef] [PubMed]
- Suerbaum, S.; Brauer-Steppkes, T.; Labigne, A.; Cameron, B.; Drlica, K. Topoisomerase I of Helicobacter pylori: Juxtaposition with a flagellin gene (flaB) and functional requirement of a fourth zinc finger motif. Gene 1998, 210, 151–161. [Google Scholar] [CrossRef]
- Tse-Dinh, Y.C. Bacterial topoisomerase I as a target for discovery of antibacterial compounds. Nucleic Acids Res. 2009, 37, 731–737. [Google Scholar] [CrossRef] [PubMed]
- Nagaraja, V.; Godbole, A.A.; Henderson, S.R.; Maxwell, A. DNA topoisomerase I and DNA gyrase as targets for TB therapy. Drug Discov. Today 2017, 22, 510–518. [Google Scholar] [CrossRef] [PubMed]
- Cheng, B.; Liu, I.F.; Tse-Dinh, Y.C. Compounds with antibacterial activity that enhance DNA cleavage by bacterial DNA topoisomerase I. J. Antimicrob. Chemother. 2007, 59, 640–645. [Google Scholar] [CrossRef] [PubMed]
- Philippe, H.; Pauline, B.; Emeline, R.; Ina, A. Pseudomonas aeruginosa renews its virulence factors. Environ. Microbiol. Rep. 2016, 8, 564–571. [Google Scholar]
- Klockgether, J.; Tummler, B. Recent advances in understanding Pseudomonas aeruginosa as a pathogen. F1000Res 2017, 6, 1261. [Google Scholar] [CrossRef] [PubMed]
- Winsor, G.L.; Griffiths, E.J.; Lo, R.; Dhillon, B.K.; Shay, J.A.; Brinkman, F.S. Enhanced annotations and features for comparing thousands of Pseudomonas genomes in the Pseudomonas genome database. Nucleic Acids Res. 2016, 44, D646–D653. [Google Scholar] [CrossRef] [PubMed]
- Das, T.; Kutty, S.K.; Tavallaie, R.; Ibugo, A.I.; Panchompoo, J.; Sehar, S.; Aldous, L.; Yeung, A.W.; Thomas, S.R.; Kumar, N.; et al. Phenazine virulence factor binding to extracellular DNA is important for Pseudomonas aeruginosa biofilm formation. Sci. Rep. 2015, 5, 8398. [Google Scholar] [CrossRef] [PubMed]
- Lau, G.W.; Ran, H.; Kong, F.; Hassett, D.J.; Mavrodi, D. Pseudomonas aeruginosa pyocyanin is critical for lung infection in mice. Infect. Immun. 2004, 72, 4275–4278. [Google Scholar] [CrossRef] [PubMed]
- Glasser, N.R.; Kern, S.E.; Newman, D.K. Phenazine redox cycling enhances anaerobic survival in Pseudomonas aeruginosa by facilitating generation of ATP and a proton-motive force. Mol. Microbiol. 2014, 92, 399–412. [Google Scholar] [CrossRef] [PubMed]
- Dietrich, L.E.; Price-Whelan, A.; Petersen, A.; Whiteley, M.; Newman, D.K. The phenazine pyocyanin is a terminal signalling factor in the quorum sensing network of Pseudomonas aeruginosa. Mol. Microbiol. 2006, 61, 1308–1321. [Google Scholar] [CrossRef] [PubMed]
- Mavrodi, D.V.; Bonsall, R.F.; Delaney, S.M.; Soule, M.J.; Phillips, G.; Thomashow, L.S. Functional analysis of genes for biosynthesis of pyocyanin and phenazine-1-carboxamide from Pseudomonas aeruginosa PAO1. J. Bacteriol. 2001, 183, 6454–6465. [Google Scholar] [CrossRef] [PubMed]
- Williams, P.; Camara, M. Quorum sensing and environmental adaptation in Pseudomonas aeruginosa: A tale of regulatory networks and multifunctional signal molecules. Curr. Opin. Microbiol. 2009, 12, 182–191. [Google Scholar] [CrossRef] [PubMed]
- Sonnleitner, E.; Haas, D. Small RNAs as regulators of primary and secondary metabolism in Pseudomonas species. Appl. Microbiol. Biotechnol. 2011, 91, 63–79. [Google Scholar] [CrossRef] [PubMed]
- Balasubramanian, D.; Schneper, L.; Kumari, H.; Mathee, K. A dynamic and intricate regulatory network determines Pseudomonas aeruginosa virulence. Nucleic Acids Res. 2013, 41, 1–20. [Google Scholar] [CrossRef] [PubMed]
- Diggle, S.P.; Winzer, K.; Chhabra, S.R.; Worrall, K.E.; Camara, M.; Williams, P. The Pseudomonas aeruginosa quinolone signal molecule overcomes the cell density-dependency of the quorum sensing hierarchy, regulates rhl-dependent genes at the onset of stationary phase and can be produced in the absence of LasR. Mol. Microbiol. 2003, 50, 29–43. [Google Scholar] [CrossRef] [PubMed]
- Liang, H.; Li, L.; Dong, Z.; Surette, M.G.; Duan, K. The YebC family protein PA0964 negatively regulates the Pseudomonas aeruginosa quinolone signal system and pyocyanin production. J. Bacteriol. 2008, 190, 6217–6227. [Google Scholar] [CrossRef] [PubMed]
- Latifi, A.; Winson, M.K.; Foglino, M.; Bycroft, B.W.; Stewart, G.S.; Lazdunski, A.; Williams, P. Multiple homologues of LuxR and LuxI control expression of virulence determinants and secondary metabolites through quorum sensing in Pseudomonas aeruginosa PAO1. Mol. Microbiol. 1995, 17, 333–343. [Google Scholar] [CrossRef] [PubMed]
- Valentini, M.; Gonzalez, D.; Mavridou, D.A.; Filloux, A. Lifestyle transitions and adaptive pathogenesis of Pseudomonas aeruginosa. Curr. Opin. Microbiol. 2018, 41, 15–20. [Google Scholar] [CrossRef] [PubMed]
- Goodman, A.L.; Kulasekara, B.; Rietsch, A.; Boyd, D.; Smith, R.S.; Lory, S. A signaling network reciprocally regulates genes associated with acute infection and chronic persistence in Pseudomonas aeruginosa. Dev. Cell 2004, 7, 745–754. [Google Scholar] [CrossRef] [PubMed]
- Hauser, A.R. The type III secretion system of Pseudomonas aeruginosa: Infection by injection. Nat. Rev. Microbiol. 2009, 7, 654–665. [Google Scholar] [CrossRef] [PubMed]
- Lee, K.; Yoon, S.S. Pseudomonas aeruginosa Biofilm, a Programmed Bacterial Life for Fitness. J. Microbiol. Biotechnol. 2017, 27, 1053–1064. [Google Scholar] [PubMed]
- Kong, W.; Chen, L.; Zhao, J.; Shen, T.; Surette, M.G.; Shen, L.; Duan, K. Hybrid sensor kinase PA1611 in Pseudomonas aeruginosa regulates transitions between acute and chronic infection through direct interaction with RetS. Mol. Microbiol. 2013, 88, 784–797. [Google Scholar] [CrossRef] [PubMed]
- Hoang, T.T.; Karkhoff-Schweizer, R.R.; Kutchma, A.J.; Schweizer, H.P. A broad-host-range Flp-FRT recombination system for site-specific excision of chromosomally-located DNA sequences: Application for isolation of unmarked Pseudomonas aeruginosa mutants. Gene 1998, 212, 77–86. [Google Scholar] [CrossRef]
- Stupina, V.A.; Wang, J.C. Viability of Escherichia coli topA mutants lacking DNA topoisomerase I. J. Biol. Chem. 2005, 280, 355–360. [Google Scholar] [CrossRef] [PubMed]
- Chen, L.; Wang, W.; Sun, W.; Surette, M.; Duan, K. Characterization of a cryptic plasmid from Pseudomonas sp. and utilization of its temperature-sensitive derivatives for genetic manipulation. Plasmid 2010, 64, 110–117. [Google Scholar] [CrossRef] [PubMed]
- Ahmed, W.; Menon, S.; Karthik, P.V.; Nagaraja, V. Reduction in DNA topoisomerase I level affects growth, phenotype and nucleoid architecture of Mycobacterium smegmatis. Microbiology 2015, 161 Pt 2, 341–353. [Google Scholar] [CrossRef]
- Beran-Steed, R.K.; Tse-Dinh, Y.-C. The carboxyl terminal domain of Escherichia coli DNA topoisomerase I confers higher affinity to DNA. Proteins 1989, 6, 249–258. [Google Scholar] [CrossRef] [PubMed]
- Yang, J.; Annamalai, T.; Cheng, B.; Banda, S.; Tyagi, R.; Tse-Dinh, Y.C. Antimicrobial susceptibility and SOS-dependent increase in mutation frequency are impacted by Escherichia coli Topoisomerase I C-terminal point mutation. Antimicrob. Agents Chemother. 2015, 59, 6195–6202. [Google Scholar] [CrossRef] [PubMed]
- Webber, M.A.; Ricci, V.; Whitehead, R.; Patel, M.; Fookes, M.; Ivens, A.; Piddock, L.J.V. Clinically relevant mutant DNA gyrase alters supercoiling, changes the transcriptome, and confers multidrug resistance. MBio 2013, 4, e00273-13. [Google Scholar] [CrossRef] [PubMed]
- Hatfield, G.W.; Benham, C.J. DNA topology-mediated control of global gene expression in Escherichia coli. Annu. Rev. Genet. 2002, 36, 175–203. [Google Scholar] [CrossRef] [PubMed]
- Travers, A.; Muskhelishvili, G. DNA supercoiling—A global transcriptional regulator for enterobacterial growth? Nat. Rev. Microbiol. 2005, 3, 157–169. [Google Scholar] [CrossRef] [PubMed]
- Hsieh, L.S.; Rouviere-Yaniv, J.; Drlica, K. Bacterial DNA supercoiling and [ATP]/[ADP] ratio: Changes associated with salt shock. J. Bacteriol. 1991, 173, 3914–3917. [Google Scholar] [CrossRef] [PubMed]
- Menzel, R.; Gellert, M. Regulation of the genes for E. coli DNA gyrase: Homeostatic control of DNA supercoiling. Cell 1983, 34, 105–113. [Google Scholar] [CrossRef]
- Snoep, J.L.; van der Weijden, C.C.; Andersen, H.W.; Westerhoff, H.V.; Jensen, P.R. DNA supercoiling in Escherichia coli is under tight and subtle homeostatic control, involving gene-expression and metabolic regulation of both topoisomerase I and DNA gyrase. Eur. J. Biochem. 2002, 269, 1662–1669. [Google Scholar] [CrossRef] [PubMed]
- Sun, Z.; Shi, J.; Liu, C.; Jin, Y.; Li, K.; Chen, R.; Jin, S.; Wu, W. PrtR homeostasis contributes to Pseudomonas aeruginosa pathogenesis and resistance against ciprofloxacin. Infect Immun. 2014, 82, 1638–1647. [Google Scholar] [CrossRef] [PubMed]
- Jimenez, P.N.; Koch, G.; Thompson, J.A.; Xavier, K.B.; Cool, R.H.; Quax, W.J. The multiple signaling systems regulating virulence in Pseudomonas aeruginosa. Microbiol. Mol. Biol. Rev. 2012, 76, 46–65. [Google Scholar] [CrossRef] [PubMed]
- Duan, K.; Surette, M.G. Environmental regulation of Pseudomonas aeruginosa PAO1 Las and Rhl quorum-sensing systems. J. Bacteriol. 2007, 189, 4827–4836. [Google Scholar] [CrossRef] [PubMed]
- Richardson, S.M.; Higgins, C.F.; Lilley, D.M. The genetic control of DNA supercoiling in Salmonella typhimurium. Embo J. 1984, 3, 1745–1752. [Google Scholar] [CrossRef] [PubMed]
- Pruss, G.J.; Manes, S.H.; Drlica, K. Escherichia coli DNA topoisomerase I mutants: Increased supercoiling is corrected by mutations near gyrase genes. Cell 1982, 31, 35–42. [Google Scholar] [CrossRef]
- DiNardo, S.; Voelkel, K.A.; Sternglanz, R.; Reynolds, A.E.; Wright, A. Escherichia coli DNA topoisomerase I mutants have compensatory mutations in DNA gyrase genes. Cell 1982, 31, 43–51. [Google Scholar] [CrossRef]
- Ni Bhriain, N.; Dorman, C.J. Isolation and characterization of a topA mutant of Shigella flexneri. Mol. Microbiol. 1993, 7, 351–358. [Google Scholar] [CrossRef] [PubMed]
- Szafran, M.; Skut, P.; Ditkowski, B.; Ginda, K.; Chandra, G.; Zakrzewska-Czerwinska, J.; Jakimowicz, D. Topoisomerase I (TopA) is recruited to ParB complexes and is required for proper chromosome organization during Streptomyces coelicolor sporulation. J. Bacteriol. 2013, 195, 4445–4455. [Google Scholar] [CrossRef] [PubMed]
- Ahmed, W.; Menon, S.; Godbole, A.A.; Karthik, P.V.; Nagaraja, V. Conditional silencing of topoisomerase I gene of Mycobacterium tuberculosis validates its essentiality for cell survival. FEMS Microbiol. Lett. 2014, 353, 116–123. [Google Scholar] [CrossRef] [PubMed]
- Valjavec-Gratian, M.; Henderson, T.A.; Hill, T.M. Tus-mediated arrest of DNA replication in Escherichia coli is modulated by DNA supercoiling. Mol. Microbiol. 2005, 58, 758–773. [Google Scholar] [CrossRef] [PubMed]
- Zumstein, L.; Wang, J.C. Probing the structural domains and function in vivo of Escherichia coli DNA topoisomerase I by mutagenesis. J. Mol. Biol. 1986, 191, 333–340. [Google Scholar] [CrossRef]
- Ahmed, W.; Menon, S.; Karthik, P.V.; Nagaraja, V. Autoregulation of topoisomerase I expression by supercoiling sensitive transcription. Nucleic Acids Res. 2016, 44, 1541–1552. [Google Scholar] [CrossRef] [PubMed]
- Tse-Dinh, Y.C. Regulation of the Escherichia coli DNA topoisomerase I gene by DNA supercoiling. Nucleic Acids Res. 1985, 13, 4751–4763. [Google Scholar] [CrossRef] [PubMed]
- Dorman, C.J.; Ni Bhriain, N.; Higgins, C.F. DNA supercoiling and environmental regulation of virulence gene expression in Shigella flexneri. Nature 1990, 344, 789–792. [Google Scholar] [CrossRef] [PubMed]
- de la Campa, A.G.; Ferrándiz, M.J.; Martín-Galiano, A.J.; García, M.T.; Tirado-Vélez, J.M. The Transcriptome of Streptococcus pneumoniae Induced by Local and Global Changes in Supercoiling. Front. Microbiol. 2017, 8, 1447. [Google Scholar] [CrossRef] [PubMed]
- Sternglanz, R.; DiNardo, S.; Voelkel, K.A.; Nishimura, Y.; Hirota, Y.; Becherer, K.; Zumstein, L.; Wang, J.C. Mutations in the gene coding for Escherichia coli DNA topoisomerase I affect transcription and transposition. Proc. Natl. Acad. Sci. USA 1981, 78, 2747–2751. [Google Scholar] [CrossRef] [PubMed]
- Wang, Y.; Lynch, A.S.; Chen, S.J.; Wang, J.C. On the molecular basis of the thermal sensitivity of an Escherichia coli topA mutant. J. Biol. Chem. 2002, 277, 1203–1209. [Google Scholar] [CrossRef] [PubMed]
- Tse-Dinh, Y.C. Increased sensitivity to oxidative challenges associated with topA deletion in Escherichia coli. J. Bacteriol. 2000, 182, 829–832. [Google Scholar] [CrossRef] [PubMed]
- DeVault, J.D.; Kimbara, K.; Chakrabarty, A.M. Pulmonary dehydration and infection in cystic fibrosis: Evidence that ethanol activates alginate gene expression and induction of mucoidy in Pseudomonas aeruginosa. Mol. Microbiol. 1990, 4, 737–745. [Google Scholar] [CrossRef] [PubMed]
- Stapper, A.P.; Narasimhan, G.; Ohman, D.E.; Barakat, J.; Hentzer, M.; Molin, S.; Kharazmi, A.; Hoiby, N.; Mathee, K. Alginate production affects Pseudomonas aeruginosa biofilm development and architecture, but is not essential for biofilm formation. J. Med. Microbiol. 2004, 53 Pt 7, 679–690. [Google Scholar] [CrossRef]
- Cheng, B.; Zhu, C.X.; Ji, C.; Ahumada, A.; Tse-Dinh, Y.C. Direct interaction between Escherichia coli RNA polymerase and the zinc ribbon domains of DNA topoisomerase I. J. Biol. Chem. 2003, 278, 30705–30710. [Google Scholar] [CrossRef] [PubMed]
- Ahmad, M.; Xu, D.; Wang, W. Type IA topoisomerases can be “magicians” for both DNA and RNA in all domains of life. RNA Biol. 2017, 14, 854–864. [Google Scholar] [CrossRef] [PubMed]
- Wu, W.; Jin, S. PtrB of Pseudomonas aeruginosa suppresses the type III secretion system under the stress of DNA damage. J. Bacteriol. 2005, 187, 6058–6068. [Google Scholar] [CrossRef] [PubMed]
- Drlica, K.; Zhao, X. DNA gyrase, topoisomerase IV, and the 4-quinolones. Microbiol. Mol. Biol. Rev. 1997, 61, 377–392. [Google Scholar] [PubMed]
- Pan, X.S.; Ambler, J.; Mehtar, S.; Fisher, L.M. Involvement of topoisomerase IV and DNA gyrase as ciprofloxacin targets in Streptococcus pneumoniae. Antimicrob. Agents Chemother. 1996, 40, 2321–2326. [Google Scholar] [CrossRef] [PubMed]
- Banda, S.; Cao, N.; Tse-Dinh, Y.C. Distinct Mechanism Evolved for Mycobacterial RNA Polymerase and Topoisomerase I Protein-Protein Interaction. J. Mol. Biol. 2017, 429, 2931–2942. [Google Scholar] [CrossRef] [PubMed]
- Yahr, T.L.; Wolfgang, M.C. Transcriptional regulation of the Pseudomonas aeruginosa type III secretion system. Mol. Microbiol. 2006, 62, 631–640. [Google Scholar] [CrossRef] [PubMed]
- Jayaseelan, S.; Ramaswamy, D.; Dharmaraj, S. Pyocyanin: Production, applications, challenges and new insights. World J. Microbiol. Biotechnol. 2014, 30, 1159–1168. [Google Scholar] [CrossRef] [PubMed]
- Ditta, G.; Stanfield, S.; Corbin, D.; Helinski, D.R. Broad host range DNA cloning system for gram-negative bacteria: Construction of a gene bank of Rhizobium meliloti. Proc. Natl. Acad. Sci. USA 1980, 77, 7347–7351. [Google Scholar] [CrossRef] [PubMed]
- Schweizer, H.P. Two plasmids, X1918 and Z1918, for easy recovery of the xylE and lacZ reporter genes. Gene 1993, 134, 89–91. [Google Scholar] [CrossRef]
- Duan, K.; Dammel, C.; Stein, J.; Rabin, H.; Surette, M.G. Modulation of Pseudomonas aeruginosa gene expression by host microflora through interspecies communication. Mol. Microbiol. 2003, 50, 1477–1491. [Google Scholar] [CrossRef] [PubMed]
- Kurach, M. Studies on the biosynthesis of pyocyanine. (II): Isolation and determination of pyocyanine. Bull. Instit. Chem. Res. 1958, 36, 174–187. [Google Scholar]
- Sakhtah, H.; Koyama, L.; Zhang, Y.; Morales, D.K.; Fields, B.L.; Price-Whelan, A.; Hogan, D.A.; Shepard, K.; Dietrich, L.E. The Pseudomonas aeruginosa efflux pump MexGHI-OpmD transports a natural phenazine that controls gene expression and biofilm development. Proc. Natl. Acad. Sci. USA 2016, 113, E3538–E3547. [Google Scholar] [CrossRef] [PubMed]
- Chambers, C.E.; Visser, M.B.; Schwab, U.; Sokol, P.A. Identification of N-acylhomoserine lactones in mucopurulent respiratory secretions from cystic fibrosis patients. FEMS Microbiol. Lett. 2005, 244, 297–304. [Google Scholar] [CrossRef] [PubMed]
- Guo, Q.; Wu, Q.; Bai, D.; Liu, Y.; Chen, L.; Jin, S.; Wu, Y.; Duan, K. Potential use of dimethyl sulfoxide in treatment of infections caused by Pseudomonas aeruginosa. Antimicrob. Agents Chemother. 2016, 60, 7159–7169. [Google Scholar] [PubMed]
- O’Toole, G.A.; Kolter, R. Initiation of biofilm formation in Pseudomonas fluorescens WCS365 proceeds via multiple, convergent signalling pathways: A genetic analysis. Mol. Microbiol. 1998, 28, 449–461. [Google Scholar] [CrossRef] [PubMed]
- Rashid, M.H.; Kornberg, A. Inorganic polyphosphate is needed for swimming, swarming, and twitching motilities of Pseudomonas aeruginosa. Proc. Natl. Acad. Sci. USA 2000, 97, 4885–4890. [Google Scholar] [CrossRef] [PubMed]
- Link, A.J.; LaBaer, J. Trichloroacetic acid (TCA) precipitation of proteins. Cold Spring Harb. Protoc. 2011, 2011, 993–994. [Google Scholar] [CrossRef] [PubMed]

© 2019 by the authors. Licensee MDPI, Basel, Switzerland. This article is an open access article distributed under the terms and conditions of the Creative Commons Attribution (CC BY) license (http://creativecommons.org/licenses/by/4.0/).
Share and Cite
Yan, R.; Hu, S.; Ma, N.; Song, P.; Liang, Q.; Zhang, H.; Li, Y.; Shen, L.; Duan, K.; Chen, L. Regulatory Effect of DNA Topoisomerase I on T3SS Activity, Antibiotic Susceptibility and Quorum- Sensing-Independent Pyocyanin Synthesis in Pseudomonas aeruginosa. Int. J. Mol. Sci. 2019, 20, 1116. https://doi.org/10.3390/ijms20051116
Yan R, Hu S, Ma N, Song P, Liang Q, Zhang H, Li Y, Shen L, Duan K, Chen L. Regulatory Effect of DNA Topoisomerase I on T3SS Activity, Antibiotic Susceptibility and Quorum- Sensing-Independent Pyocyanin Synthesis in Pseudomonas aeruginosa. International Journal of Molecular Sciences. 2019; 20(5):1116. https://doi.org/10.3390/ijms20051116
Chicago/Turabian StyleYan, Rong, Shikun Hu, Ning Ma, Peiqing Song, Qingqing Liang, Huiqun Zhang, Yanqi Li, Lixin Shen, Kangmin Duan, and Lin Chen. 2019. "Regulatory Effect of DNA Topoisomerase I on T3SS Activity, Antibiotic Susceptibility and Quorum- Sensing-Independent Pyocyanin Synthesis in Pseudomonas aeruginosa" International Journal of Molecular Sciences 20, no. 5: 1116. https://doi.org/10.3390/ijms20051116
APA StyleYan, R., Hu, S., Ma, N., Song, P., Liang, Q., Zhang, H., Li, Y., Shen, L., Duan, K., & Chen, L. (2019). Regulatory Effect of DNA Topoisomerase I on T3SS Activity, Antibiotic Susceptibility and Quorum- Sensing-Independent Pyocyanin Synthesis in Pseudomonas aeruginosa. International Journal of Molecular Sciences, 20(5), 1116. https://doi.org/10.3390/ijms20051116

